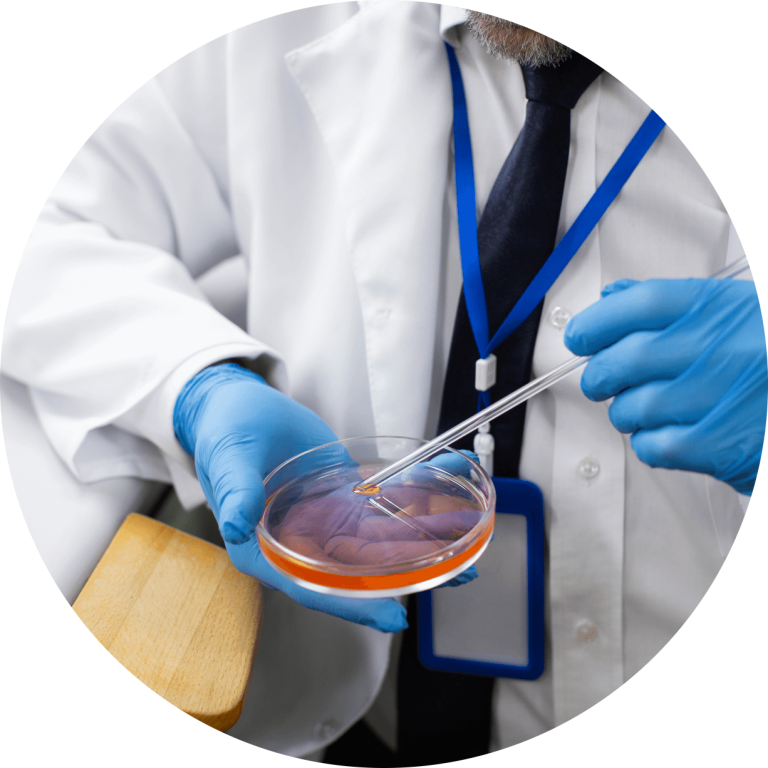

Wound Expert, Specialized Care for Faster, Safer Healing

Wound Expert, Specialized Care for Faster, Safer Healing
When it comes to wound care, not all providers are created equal. A wound expert is a medical professional specially trained in diagnosing, treating, and managing both simple and complex wounds. Whether you’re dealing with a surgical incision, diabetic ulcer, infected cut, or pressure sore, our certified wound care specialists are here to help you heal correctly and completely.
What Is a Wound Expert?
A wound expert, also known as a wound care specialist or certified wound clinician, is trained to:
Assess and categorize all types of wounds
Create personalized wound treatment plans
Prevent and treat infections
Manage chronic or slow-healing wounds
Recommend the right dressings, ointments, and therapies
Educate patients on home wound care and prevention
Healing faster isn’t luck, it’s expertise.


When to See a Wound Expert
You should consult a wound care specialist if you have:
- A wound that hasn’t healed within 2–3 weeks
- Signs of infection (redness, pus, swelling, odor)
- Surgical wounds with complications
- Pressure ulcers, diabetic foot ulcers, or venous leg ulcers
- Burns, lacerations, or trauma-related wounds
- Chronic wounds due to poor circulation or other conditions
Our Approach to Expert Wound Care
We combine evidence-based medicine with cutting-edge techniques to ensure optimal healing:
- Comprehensive assessments and digital wound tracking
- Advanced wound cleansing and debridement
- Prescription wound treatments and antibiotic management
- Coordination with labs for cultures and diagnostics
- Patient education and prevention strategies


In-Person and Virtual Wound Consultations Available
Whether you need hands-on treatment or remote guidance, our wound experts are available through in-clinic visits and secure telehealth appointments. We’ll help you assess the wound, identify risks, and follow a personalized healing plan.
Covered by Most Insurance Plans
We work with a wide range of insurance providers, and we also offer affordable self-pay pricing for consultations and treatment.

Start Healing with Confidence
Don’t risk improper healing or long-term complications. Trust your recovery to a true wound expert.
Our team is committed to delivering expert care with precision, compassion, and clinical excellence—because every wound deserves the right treatment from the start.
No guesswork. No delays. Just the specialized care your body needs to heal safely and fully.
Book a Wound Specialist Appointment Now
Advanced Technology for Superior Wound Healing
Mention of NPWT (Negative Pressure Wound Therapy): This is indeed referenced on the WCDC site in product categories and aligns with common advanced wound care protocols.
Bioengineered skin substitutes, enzymatic debriders: These are standard, medically accepted treatments used by wound care providers and are supported by WCDC’s product offerings (e.g., collagen dressings, biosynthetic dressings).
Focus on tissue regeneration and infection control: Matches both best practices in wound healing and the clinical language used across the WCDC site.
Collaborative Care for Complex Cases
Interdisciplinary approach: WCDC emphasizes collaboration with wound care centers, physicians, hospitals, and skilled nursing facilities. Chronic wound care often requires coordination with specialists (e.g., vascular or endocrinology), which is a standard, medically accurate claim.
Addressing systemic conditions like diabetes, poor circulation: These are primary underlying causes of chronic wounds, mentioned directly or indirectly across the site and in the wound care industry at large.
Trusted Products. Proven Results
FDA-compliant, medically backed supplies: The company clearly outlines its adherence to industry standards and lists product lines that are widely recognized and FDA-approved.
Reference to collagen, antimicrobial dressings, etc.: These are core categories sold on the site.
Emphasis on outcomes and evidence-based care: Matches both the site’s tone and the expectations of the clinical audience it serves.
Our Commitment to Excellence
Join the Next Generation of Wound Care
If you’re seeking truly innovative wound care dressings backed by science, support, and results — Wound Care Distribution Center is your trusted partner.
